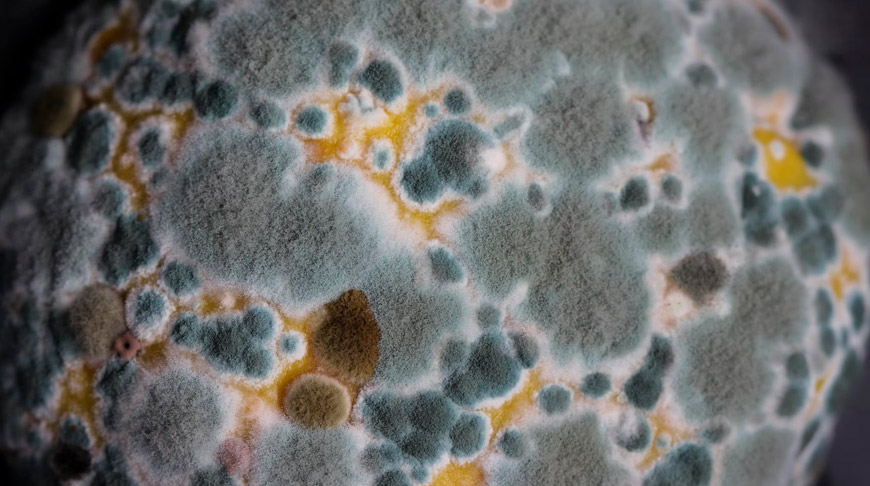

Летом продукты куда быстрее "зацветают": для грибков жара и влажность - лучшие условия. Но если одни продукты можно спасти, убрав плесень, то другие лучше выбросить сразу - они уже опасны для здоровья. Разбираемся с врачом-гигиенистом, достаточно ли срезать у яблока гнилой бочок, а у варенья убрать мохнатую верхушку, как понять, что хлеб испорчен еще до появления на нем пятнышек и какой их цвет говорит о смертельной опасности для человека.
Хуже ядовитых грибов
В корзине опытного грибника вы никогда не найдете ни мухомора, ни бледной поганки, ни им подобных, ведь они ядовиты. Но в домашней продуктовой корзинке у некоторых периодически появляются ничуть не менее опасные пенициллиумы, фузариумы и аспергиллезы.
- Они микроскопические, глазу не видны. Но эти виды грибов содержат яды - микотоксины, которые попадают в организм с пищей. Встречаются практически во всех видах пищевых продуктов, особенно растительного происхождения. Поражают их на любом этапе производства: в поле, во время уборки урожая, его транспортировки, хранения, в процессе приготовления в домашних условиях. Заплесневелые сельхозпродукты, зерно, фураж вызывают у животных и людей микотоксикозы, - объясняет врач-гигиенист санитарно-эпидемиологического отдела ГУ "Центр гигиены и эпидемиологии Ленинского района г. Минска" Наталия Чернявская.
Грибы со временем погибают, но в продуктах остаются токсины. Избавиться от них практически невозможно. Попав в организм, они воздействуют на печень, почки, кроветворные органы, вызывая мутации и раковые заболевания. Кроме того, в испорченных продуктах могут активизироваться возбудители сальмонеллеза, очень неприятного заболевания со множеством побочных эффектов.
Какая плесень самая ядовитая?
- Хлеб часто поражается плесенью, особенно если долго хранится при температуре +10 - +35°С и высокой влажности. Если пятен на корочке или мякише еще не видно, но на вкус чувствуется горечь, есть запах гнили, то употреблять его в пищу уже нельзя. На хлебе в герметичной вакуумной упаковке плесневые грибы появляются реже, - отмечает медик.
Самые ядовитые - желтая плесень и черная гниль. Первая выделяет афлатоксин, который вызывает у человека тяжелейшие поражения легких и даже может привести к смерти. Вторая продуцирует алкалоид фумигоклавин, грозящий тяжелой интоксикацией и аспергиллезом - инфекцией, поражающей верхние дыхательные пути. Кроме того, длительное воздействие плесени может привести к внутреннему кровотечению в желудке, нарушениям в работе почек, печени.
Неаппетитные пятнышки гнили на боках яблок, груш, айвы, абрикосов, персиков, клубники, помидоров, картофеля, огурцов выдают в них содержание такого яда, как патулин, который снижает иммунитет человека.
- Некоторые считают, что достаточно срезать у овоща или фрукта подгнившую часть и его можно есть. Это не так. Заплесневелые продукты уже глубоко поражены грибком. Даже когда вы уберете гнилой бочок с овощей, фруктов, сыра или хлеба, это не защитит от риска отравления. Если вам в руки попал испорченный продукт, заверните его в целлофан и выбросите. Не подносите близко к слизистым носа и глаз, особенно если страдаете от аллергии - споры плесени попадут с вдыхаемым воздухом в легкие. После того, как выбросите заплесневелый продукт, обработайте дезинфицирующим средством место, в котором он лежал. Обязательно со всех сторон осмотрите лежавшие рядом припасы, - советует Наталия Чернявская.
Она рекомендует избавиться и от любых консервов, в том числе от варенья, если в банке появилось хотя бы небольшое пятнышко плесени. И предостерегает варить компоты из испорченных грибком сухофруктов - высокая температура на яды не действует.

Есть ли полезная плесень?
- Кроме вредной плесени, о которой мы говорим, есть и благородная. Разница между ними примерно такая же, как между белым грибом и поганкой. Благородная плесень - это разновидность полезных грибковых культур Penicillium и других, которые придают вкус сырам, колбасам. Она не только не вредна для здоровья, но даже приносит ему определенную пользу: нормализует работу кишечника и снижает риск развития сердечно-сосудистых патологий, поскольку является естественным консервантом для продуктов, - отмечает врач-гигиенист.
Наталия Чернявская объясняет, как правильно хранить припасы, чтобы на них не появлялась вредная плесень:
- Открывая герметичную упаковку, помните, что сроки годности продуктов в таком состоянии резко сокращаются. Фрукты и овощи, хлебобулочные изделия, орехи, специи храните в прохладном и сухом месте. Не покупайте продукты в больших количествах - лучше чаще освежать их набор в магазине. Ни в коем случае не становитесь клиентами торговцев с рук. Этот товар не проходит исследований в лаборатории, и продавец не может гарантировать его безопасность для вашего здоровья. Но даже если вы обнаружили дома продукт с плесенью, ни в коем случае не скармливайте его животным. Для их организма яды так же опасны, как и для человеческого, - предупреждает медик.
| Материал газеты "7 дней", фото из открытых интернет-источников.
Читайте также:
Сколько лет можно хранить варенье и домашние заготовки?
Как убрать запах из холодильника
Зачем "обманывать" бактерии? Разработки Института биоорганической химии НАН вас удивят
- размещаются материалы рекламно-информационного характера.